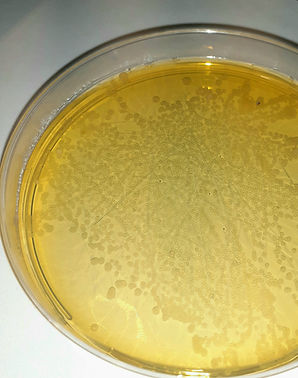
agarHögt.jpg

Analyser
I dagsläget erbjuds endast analys av Amerikansk Yngelröta,
i form av förebyggande provtagning av vuxna bin
Just nu är det många som frågar om Europeisk Yngelröta. Den kan inte analyseras här. Även om de är lika till namnet orsakas sjukdomarna av helt olika bakterier som kräver olika metoder och utrustning.
Kontakta alltid bitillsynen vid symptom på yngelsjukdom
Då sporer av amerikansk yngelröta analyseras anges resultatet i tre olika svarskategorier:

Varje "prick" på odlingsplattan motsvarar en bakterie, vid hög förekomst täcker de ofta hela
Ingen förekomst
Inga bakterier har hittats.
Resultatet du vill ha,
men ha också i åtanke att resultatet alltid är en ögonblicksbild vid tillfället då provet togs.
Låg-måttlig förekomst
Vid ett svar i den här kategorin behöver en bedömning på lämpliga åtgärder göras, utifrån mängd bakterier men också biodlarens förutsättningar.
Hög förekomst
Hög risk för att symptom redan är på väg att utvecklas. Åtgärder behöver vidtas omgående och i de flesta fall rekommenderas att kontakta bitillsynen för en bedömning.